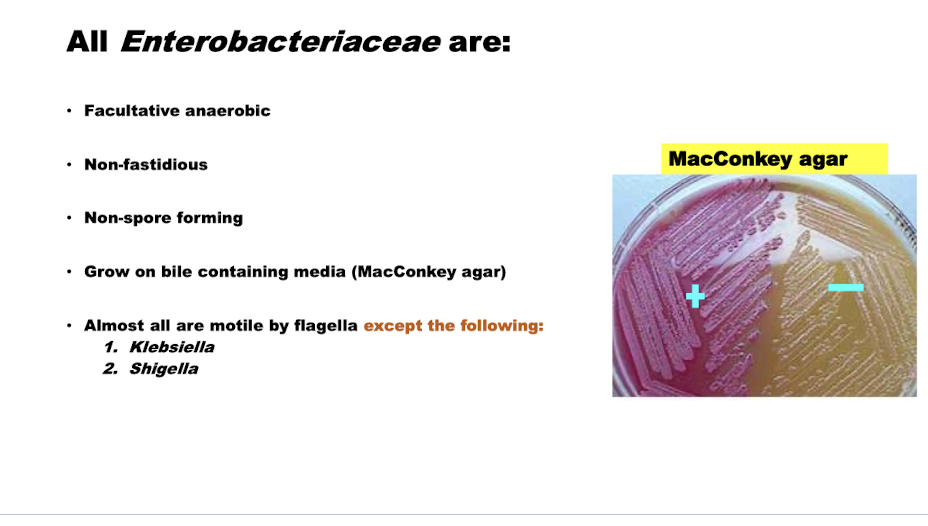

What are the 8 important enterobacteriaceae?

What are the characteristics of enterobacteriaceae?

What of the 8 bacteria are lactose fermentors? Which are not? Which is more pathogenic lactose or non lactose fermentors?

What are more characteristics of enterobacteriaceae?


What are some biochemical tests s for identification of the different genera of Enterobacteriaceae?

What are the important characteristics shared by all enterobacteriaceae?
What is the usual habitat of enterobacteriaceae?

What is the transmission route of enterobacteriaceae?

What are the greatest impacts of enterobacteriaceae in humans and animals?

What is a large concerning symptom for enterobacteriaceae? What can it lead to?

What are the virulence factors of enterobacteriaceae?

What are the different things that lead to antigenic diversity with enterobacteriaceae?

What are the different culture media used and their interactions with enterobacteriaceae?

Why is enterobacteriaceae a global threat?



What are the major characteristics of salmonella?

What culture media is used often for Salmonellas?


What is the normal habitat of Salmonella?

What are the routes of transmission for Salmonella? What is entry? What is exit?

How many species of Salmonellas are there? What is important about them?


What are the 3 clusters of subspecies of Salmonella?





















